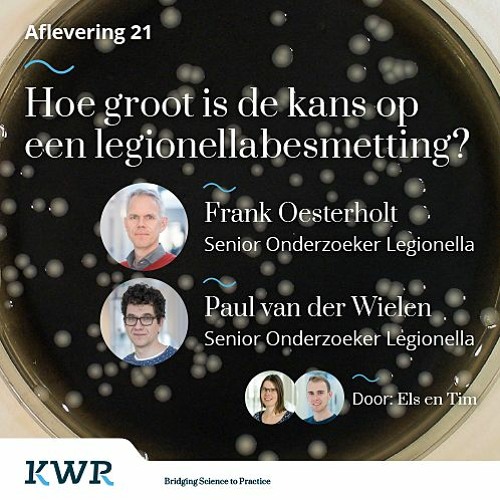

Hoe groot is de kans op een drieling? De kans op een spontane drieling is erg klein. Ongeveer 1 op de 7000 geboorten is een drieling. Naarmate de ouders ouder worden, neemt de kans op een meerlingzwangerschap toe. Bij vruchtbaarheidsbehandelingen, zoals IVF of ICSI, is de kans op een drieling groter, doordat er soms meerdere bevruchte eicellen.. De kans op een spontane tweelingzwangerschap neemt toe met de leeftijd van de zwangere. Zo is de kans op het krijgen van een tweeling voor een 25-jarige vrouw ongeveer 1 op 90 en voor een 40-jarige vrouw 1 op 60. Het grootst is de kans op een meerlingzwangerschap bij behandelingen die het ontstaan van een zwangerschap bevorderen.

De Kans Op Deze Drieling Is 1 Op 500 Biljoen Door Een Zeer Boeiende Reden YouTube

Hoe groot is de kans op een Visserijdag 2023? Flessenpost uit Egmond

Hoe groot is jouw kans op een tweeling? 24Baby.nl

46jarige moeder bevalt van gezonde identieke drieling de kans is '1 op 20 miljard'

Moeder Bevalt Van Drieling. Dokter Enorm Verbaasd Kans Is 1 In 200 Miljoen YouTube

Kans van 1 op 100.000 eeneiige drieling geboren in Putten Foto bndestem.nl

Dokter kan zijn ogen niet geloven na het zien van de gezichtjes van deze drieling Page 5

Hoe groot is de kans?

Hoe Groot Is De Kans Om Zwanger Te Worden Alle Feiten En Cijfers Uitgelegd

Dit zijn de voordelen van een drieling

Atelier Pippilotta 2012 januari

Klein wonder in Zevekote drieling kalfjes geboren (en die kans is 1 op 100.000) Gistel In
Stream Aflevering 21 Hoe groot is de kans op een legionellabesmetting? Met Oesterholt en Van

Hoe groot is de kans op een zwangerschap na seks of eisprong? Mamaliefde.nl

Baby 3 Watermethode Ouders

Hoe groot is de kans op een witte kerst in 2023? Libelle

Dokter kan zijn ogen niet geloven na het zien van de gezichtjes van deze drieling Page 3

Hoe groot is de kans op een rechts

Verlaten siamese drieling werd gered en kreeg een tweede kans Drieling Madeline, Macey en

Hoe groot is de kans dat God bestaat? YouTube
Ook tussen de 30 en 35 jaar is je kans op een tweeling al iets groter dan in je twintiger jaren: zo'n 1,7 procent; De kans op een drieling, vierling, vijfling of zesling: De kans op een drieling of nog-meerling is in Nederland klein: maar 1 op de 7000 stellen overkomt dit. Je kunt een natuurlijke drieling krijgen als je een dubbele eisprong.. De kans op een spontane tweelingzwangerschap neemt toe met de leeftijd van de zwangere; zo is de kans op het krijgen van een tweeling voor een 25-jarige vrouw ongeveer 1 op 90 en voor een 40-jarige vrouw 1 op 60.. Verschillen deze, dan is de tweeling in elk geval twee-eiig. Zijn ze hetzelfde, dan is de kans heel erg groot dat het om een.